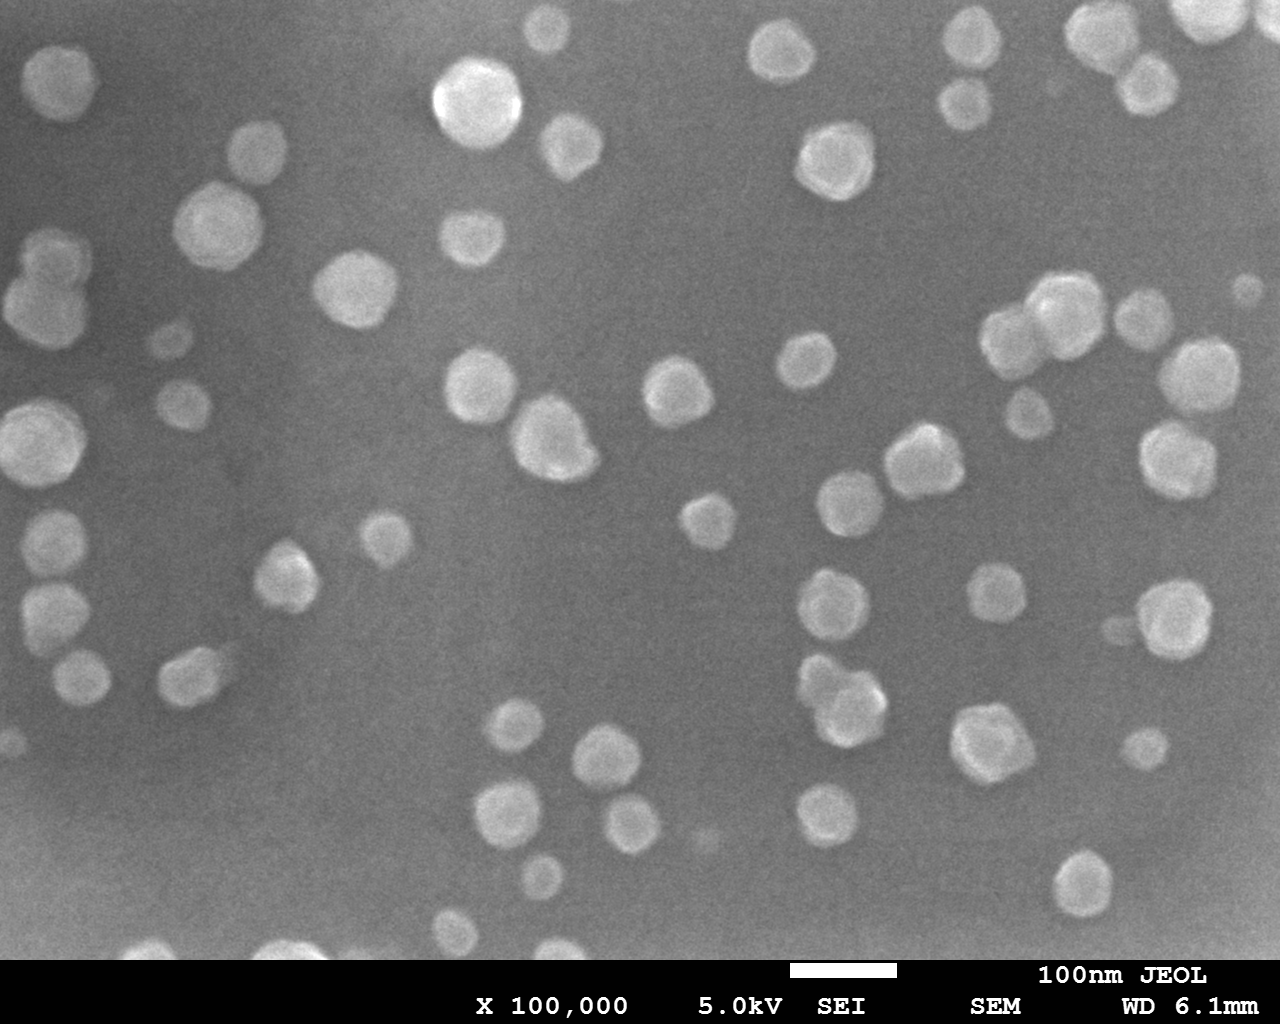

热处理工艺对铝硅酸盐微晶玻璃断裂韧性的影响毕业论文
2020-02-19 15:33:49
摘 要
铝硅酸盐微晶玻璃具有高硬度、突出的抗折强度和耐冲击强度,而且膨胀系数较低等特点,通过控制晶化工艺,可实现透明、半透明、不透明产品的制备。因此,铝硅酸盐微晶玻璃具有突出的理化性能,广泛应用于光电显示、电子元器件等领域,并引起国内外学者的广泛关注。
本文通过对一定组成的铝硅酸盐微晶玻璃进行DSC测试,得到其玻璃转变温度Tg和玻璃析晶温度Ts,然后根据Tg和Ts来制定一系列不同的晶化制度,即改变核化温度和时间及晶化温度和时间,对得到的微晶玻璃进行各项性能的测试以及对产生晶体的数量、种类和个数观察,得到晶化制度和微晶玻璃各项性能之间的关系,尤其是对于断裂韧性的影响。对晶相和性能进行了比较,所得结果对于科研和市场具有重要的指导意义。
研究结果表明:该掺入了3 wt% P2O5的特定组成的铝硅酸盐基础玻璃的粘度在1070℃到1470℃间呈线性下降趋势。通过差示扫描量热法(XRD)和扫描电镜(SEM)的结果,可以看出600℃/8h-750℃/6h,650℃/8h-750℃/1h两种晶化制度下均有球状晶体生成。晶体颗粒通过扫描照片可以看出,只有50-100个纳米左右,因此也验证了XRD没有检测到任何晶相的原因,晶粒颗粒太小。而前者热处理制度下的微晶玻璃相比于后者析出了更多的晶体。晶化后的微晶玻璃的折射率相对于未晶化的玻璃,折射率都有所下降。但在不同晶化制度处理下,得到的微晶玻璃的折射率仅出现极小的变化,考虑到误差影响,这些极小的变化可以忽略不计,即在设计的晶化制度下,玻璃的折射率几乎不变,折射率在1.54左右。同时也说明了晶化生成的晶体相很少,侧面印证了XRD结果。硬度方面,相对于未晶化的玻璃(硬度为702.34HV),不同晶化制度下的微晶玻璃的硬度具有不同程度的变化,其中600℃/8h-725℃/2h微晶玻璃的硬度达到最大,即749.24HV。相对于未晶化的玻璃(KIC=1.03MPa·m1/2),其中600℃/8h-750℃/6h的断裂韧性最大,为1.23 MPa·m1/2。
本文的特色:通过研究热处理制度对添加了3 wt% P2O5的Li2O-MgO-Al2O3-SiO2系微晶玻璃的高温粘度、热处理制度、析晶、以及晶化后的玻璃的折射率、硬度、断裂韧性的研究,提高了微晶玻璃的各项性能尤其是断裂韧性,为适用于移动终端的应用提供可能。
关键词:铝硅酸盐;热处理制度;核化;晶化;断裂韧性
Abstract
Aluminosilicate glass-ceramics have the characteristics of high hardness, outstanding bending strength and impact strength, and low expansion coefficient. Transparent, translucent and opaque products can be prepared by controlling the crystallization process. Therefore, aluminosilicate glass has outstanding physical and chemical properties, which is widely used in optoelectronic display, electronic components and other fields, and has attracted the attention of scholars at home and abroad.
In this paper, through the DSC test of certain composition of aluminosilicate glass-ceramics, the glass transition temperature Tg and glass crystallization temperature Ts, were obtained, and then a series of different crystallization systems were established according to Tg and Ts. That is, by changing the nucleation temperature and time and the crystallization temperature and time, the properties of the obtained glass-ceramics are tested and the number, type and number of crystals are observed, and the relationship between the crystallization system and the properties of glass-ceramics is obtained. Especially the effect on fracture toughness can be vividly observed. The crystal phase and properties are compared, and the results are of great significance for scientific research and market.
The results show that the viscosity of the aluminosilicate base glass mixed with 3 wt% P2O5 decreases linearly between 1070 ℃ and 1470 ℃. Through the results of differential scanning calorimetry (XRD) and scanning electron microscope (SEM), it can be seen that spherical crystals are formed under the two crystallization systems of 600℃/8h-750℃/6h,650℃/8h-750℃/1h. The results of differential scanning calorimetry (DSC) and scanning electron microscope (SEM) showed that spherical crystals were formed in both crystallization systems. The crystal particles can be seen by scanning photos, only about 50-100 nanometers, so it is also confirmed that XRD does not detect any crystal phase, the grain particles are too small. However, the glass-ceramics under the former heat treatment system precipitated more crystals than the latter. Compared with the amorphous glass, the refractive index of the crystallized glass-ceramics decreased. However, under different crystallization systems, the refractive index of glass-ceramics changes only slightly. Considering the effect of error, these minimal changes can be ignored, that is, under the designed crystallization system, the refractive index of glass-ceramics is almost unchanged. The refractive index is about 1.54. At the same time, it also shows that there are few crystal phases formed by crystallization, and the XRD results are confirmed on the side. In terms of hardness, compared with the amorphous glass (the hardness is 702.34HV), the hardness of glass-ceramics under different crystallization systems changes in varying degrees, among which the hardness of 600℃/8h-725℃/2h glass-ceramics is the highest, that is, 749.24HV. Compared with the amorphous glass (KIC=1.03MPa·m1/2), the fracture toughness of glass-ceramics under different crystallization systems changes in different degrees. Among them, 600℃/8h-750℃/6h has the highest fracture toughness. It was 1.23MPa·m1/2.
The characteristics of this paper are as follows: by studying the heat treatment system, the high temperature viscosity, heat treatment system, crystallization and the refractive index, hardness and fracture toughness of Li2O-MgO-Al2O3-SiO2 glass-ceramics with 3 wt% P2O5 were studied. It improves the properties of glass-ceramics, especially the fracture toughness, and provides the possibility for the application of mobile terminals.
Key Words:Aluminosilicate; heat treatment system; nucleation; crystallization; fracture toughness
目 录
摘 要 I
Abstract II
第1章 绪论 2
1.1 微晶玻璃 2
1.1.1 铝硅酸盐微晶玻璃 2
1.2 断裂韧性 3
1.2.1 普通玻璃的断裂韧性 3
1.2.2 微晶玻璃的断裂韧性 4
1.3 断裂韧性的测试方法 4
1.3.1 单边切口梁技术 4
1.3.2 压痕法 4
1.4 断裂韧性的影响因素 5
1.4.1 热处理制度 5
1.5 研究目的与意义 6
1.5.1 研究目的 6
1.5.2 研究意义 6
1.6 研究内容 7
第2章 实验 8
2.1实验原料与仪器设备 8
2.2 实验过程 9
2.2.1 玻璃组分 9
2.2.2 玻璃的熔制 10
2.2.3 样品制备 10
2.2.4 制备玻璃过程中出现的问题 11
2.3 测试及表征方法 11
2.3.1.差式扫描量热分析(DSC) 11
2.3.2 X射线衍射定性分析(XRD) 12
2.3.3 硬度 12
2.3.4 扫描电镜(SEM) 12
2.3.5 高温粘度 13
第3章 基质玻璃及微晶玻璃结构与性能的研究 14
3.1 引言 14
3.2热处理制度的确定 14
3.3 基质玻璃的粘度 16
3.4 热处理制度对微晶玻璃析晶的影响 18
3.4.1 XRD测试结果 18
3.4.2 SEM测试结果 19
3.4 微晶玻璃的折射率 20
3.5 微晶玻璃的硬度 20
3.6 微晶玻璃的断裂韧性 23
第4章 结论 27
参考文献 29
致 谢 30
第1章 绪论
在5G通讯已然提上日程的今天,移动终端使用率即将步入一个新台阶,而伴随而来的手机大屏的普及,也要求着屏幕质量的进一步提升,因而对于玻璃的各项性能,尤其是对于高硬度、高断裂韧性的追求已成为手机厂商争相抢占的险滩,也是玻璃制造企业当下不可轻易错失的机会,毕竟身处时代的洪流里,不进则退。而在众多种类的玻璃中,各项性能都十分优秀的微晶玻璃早已脱颖而出,研究与开发都已走在路上,也必然成为玻璃行业的重要战略目标和未来的支柱技术。
1.1 微晶玻璃
微晶玻璃又称玻璃陶瓷,是一种通过特定的核化及晶化制度来生成的含有晶体相的非传统玻璃制品,其内部同时具有晶体相和玻璃相,相比于普通玻璃令人头疼的脆性,微晶玻璃具有更高的、更优秀的强度、硬度和断裂韧性,是当下时代发展所需的重要基础材料。微晶玻璃是一种无机的非金属材料,它含有残留的玻璃相和一个或多个嵌入的晶相,这些晶相是通过不同的加工方法控制晶化而产生得到的,通过数量、大小及不同的种类,加强了基础母性玻璃的各项性能或是某一性能。由于微晶玻璃的化学组成、结晶度、热历史、添加剂、晶核剂、晶体尺寸和形貌等因素的影响,其具有优于母相玻璃的力学性能,具有较高的抗折强度和断裂韧性。通过加入一定量的某类晶核剂到具有特定组分的基础玻璃中,并经过熔融与制定的、特定的热处理工艺,使玻璃中析出大量所需的微晶相,得到含有晶体相和玻璃相的一种多晶固体材料,就是微晶玻璃。微晶玻璃具有密度低、导热系数低、抗热震性好、比强度高等优点。此外,微晶玻璃便于快速建造,运输成本低。
1.1.1 铝硅酸盐微晶玻璃
R2O-RO-Al2O3-SiO2微晶玻璃具有高硬度、突出的抗折强度和耐冲击强度等优势,而且膨胀系数较低,通过控制晶化工艺,可实现透明、半透明、不透明产品的制备。因此,根据R2O-RO-Al2O3-SiO2微晶玻璃所具有的突出的理化性能,其广泛应用于光电显示、电子元器件等领域,并引起国内外学者的广泛关注。
Li2O-Al2O3-SiO2 系微晶玻璃最主要的特性是其热膨胀系数可以在很大范围内调整,且同时具有强度高、易成型和硬度大等特点,可用于制造耐热炊具、加工刀具、滚珠轴承、天文望远镜、烧嘴等[1]。MgO-Al2O3-SiO2系微晶玻璃中最重要的是堇青石型微晶玻璃, 这种材料具有低介电系数、高力学性能、低膨胀系数、电绝缘性良好及抗热震性等特性,广泛应用于如雷达绝缘体、天线罩、电容器、整流罩、混频器和滤波器、微电子基板封装等[2]。ZnO-Al2O3-SiO2系微晶玻璃分为三类主晶相分别是:锌尖晶石、硅锌矿以及以β-石英固溶体或者透锌长石。这类材料不仅膨胀系数低、电阻高而且化学稳定性极其优秀,可以用于电磁灶面板和电气元件等方面[3]。
常见的碱金属氧化物Na2O,K2O经常作为助熔剂,本文拟在Na2O的基础上,掺加少量K2O,同时引入少量的Li2O,对微晶玻璃的熔化温度和粘度都影响很大,并且改变了晶体组成,因此本文也掺加一定量的Li2O。在玻璃中P2O5具有其他氧化物所不具有的独特的不对称结构,在硅酸盐高温熔体中,P2O5易于出现分相与析晶的情况,P2O5与 B2O3在玻璃的组成中,两者形成结构相近似,在表面张力作用方面的影响两者也极其类似,都属于组成玻璃的氧化物中的中间活性组份。也就是说,为了能够有效降低玻璃相的表面张力,P2O5与K2O、B2O3都是能够提升这项性能的常见常用组份。为使微晶玻璃的粘度有效提高,通常可以通过进行适量的ZrO2添加,而伴随着ZrO2的添加,微晶玻璃的析晶温度会显著升高。同时,微晶玻璃主晶相类型并不会随着ZrO2的添加而改变,但微晶玻璃中的某些半径较小的离子会被Zr4 离子置换,微晶玻璃的晶格常数便会因为半径更大的Zr4 离子而增大[4]。再加入碱金属氧化物助熔剂,在降低玻璃熔点同时,可以降低能耗,因此玻璃的性能在添加碱金属氧化物后不受影响,甚至玻璃的某些性质还能得到增强,符合当前全球倡导的节能环保的号召。
1.2 断裂韧性
断裂韧性表征的是某类材料阻止其内部裂纹在内部扩展延伸的能力大小,是度量材料的韧性好坏强弱的一个重要定量指标。对某种特定的材料而言,在恒温恒压下,控制对其增加荷载的速度处于一定的条件下,得到的断裂韧性是一个常数。材料内部裂纹本身的大小、形状及外加应力的大小不会决定材料断裂韧性的强弱,断裂韧性是该材料本身固有的特性,只与材料本身化学组成、制定的热处理制度及后期相关的加工工艺有关。
Griffith认为 , 相当数量的结构缺陷存在于脆性固体材料内,导致陶瓷材料、玻璃材料在低应力水平情况下断裂而致使材料不再符合应用要求的根本原因,就是这些缺陷——裂纹。但限制脆性材料最大的断裂韧性的因素不是这些裂纹的数量,而是这些裂纹中最大裂纹的尺寸。众所周知,结构影响性能,陶瓷材料裂纹扩展的路径也受到陶瓷材料的显微结构极其严重的影响,因而材料的断裂韧性也会很大程度上地受到影响 。在陶瓷材料中,张开型 (Ⅰ)、滑开型(Ⅱ)和撕开型 (Ⅲ) 是现今对于裂纹扩展研究总结得到的三种基本形式, 其中张开型(Ⅰ)——裂纹在与裂纹方向垂直的拉应力的持续作用下,沿拉应力方向产生扩展速率极快的张开位移, 是截止目前发现的最常见和最危险的类型。具有Ⅰ型裂纹系统材料所能稳定承受并使之能始终保持原有性能的外加应力场强度的极限值就是断裂韧性 KIC,当材料的断裂韧性被外加应力场强度KI在数值上达到或超过时,材料的裂纹将迅速得到扩展,材料将失去原有的强度[5] 。
以上是毕业论文大纲或资料介绍,该课题完整毕业论文、开题报告、任务书、程序设计、图纸设计等资料请添加微信获取,微信号:bysjorg。
相关图片展示:

您可能感兴趣的文章
- 改善锂离子电池中硅基负极存储性能的策略研究外文翻译资料
- 通过添加压电材料BaTiO3提高大功率锂离子电池的微米级SiO @ C/CNTs负极的电化学性能外文翻译资料
- Pd和GDC共浸渍的LSCM阴极在固体氧化物电解池高温电解CO2中的应用外文翻译资料
- 利用同步回旋加速器粉末衍射的方法来研究在有其他物相的情况下C4AF的水化作用外文翻译资料
- 外国循环流化床锅炉发展现状外文翻译资料
- 含石蜡基复合材料的多壁碳纳米管的热性能外文翻译资料
- 矸石电厂炉渣机制砂的应用研究外文翻译资料
- 机动车螺旋弹簧的失效分析外文翻译资料
- 从废阴极射线管和锗尾矿制备高强度玻璃泡沫陶瓷外文翻译资料
- 作为导热液体的液态金属在太阳能储热中的应用外文翻译资料


